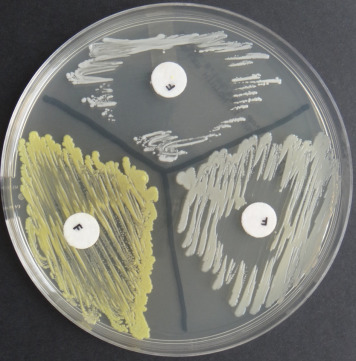
- Furazolidone disk test

Furazolidone (furoxone) susceptibility test is performed as a disk susceptibility procedure using commercially available furazolidone disks.
Staphylococci are inhibited by furazolidone, but micrococci and related species are resistant. This is one of the commonly used methods for differentiatingstaphylococci from micrococci. Â Micrococci usually grow right up to the edge of the 6-mm furazolidone disk.

Furoxone (furazolidone) is one of the synthetic antimicrobial nitrofurans with antiprotozoal and antibacterial activity. Furazolidone binds bacterial DNA which leads to the gradual inhibition of monoamine oxidase.
However, coagulase-negative staphylococci that are resistant to furazolidone may be seen occasionally.
Reagents
- Furazolidone disks, 100 μg
- Mueller-Hinton agar plate
Quality Control
Known strains of Staphylococcus (either S. aureusor a coagulase-negative strain) and Micrococcusspecies should be tested with each new lot of disks or weekly.
Procedure
- Prepare a suspension of the organism to be tested in sterile distilled water or broth. The suspension should be equivalent to a 0.5 McFarland turbidity standard.
- With a swab, spread the organism suspension onto one-half of a Mueller-Hinton agar plate.
- Aseptically place a furazolidone disk in the center of the inoculated area and gently tap the disk so that it adheres to the agar surface.
- Incubate the plate at 35°C in an ambient air incubator for 18–24 hours.
Results and Interpretations
- Furazolidone Resistant: Zone of inhibition ≤ 9 mm. E.g. Micrococcus luteus
- Furazolidone Sensitive: Zone of inhibition > 15 mm. E.g. Staphylococcus aureus, Staphylococcus saprophyticus
Uses
Furoxone susceptibility testing is done for the differentiation of micrococci (which are resistant) from staphylococci (which are sensitive).
References
- Baker J. S. (1984). Comparison of various methods for differentiation of staphylococci and micrococci. Journal of clinical microbiology, 19(6), 875–879. https://doi.org/10.1128/jcm.19.6.875-879.1984
- Devriese L. A. (1975). Furazolidone sensitivity tests with escherichia coli and staphylococcus aureus strains of animal origin. Zentralblatt fur Veterinarmedizin. Reihe B. Journal of veterinary medicine. Series B, 22(3), 220–229. https://doi.org/10.1111/j.1439-0450.1975.tb00582.x